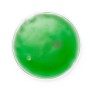
Chaufferette - Kison

Référence 00041LAB0098324
Chaufferette transparente réutilisable avec gel coloré.ø100×10 mm
Fiche technique

Chaufferette - Kison
check_circle
check_circle